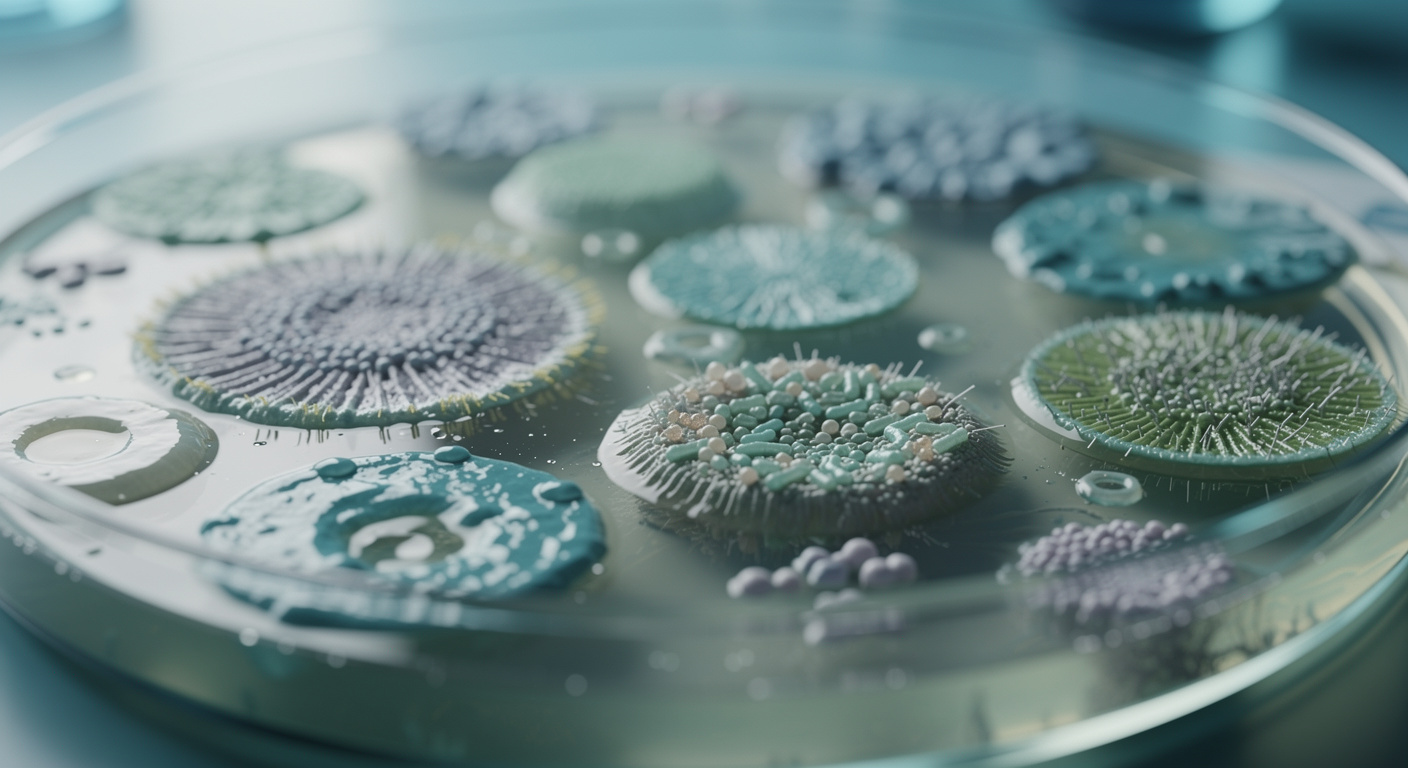

Un nouvel outil CRISPR se propage chez les bactéries pour désactiver les gènes de résistance aux antibiotiques
Auteur: Mathieu Gagnon
Une course contre la montre face aux super-bactéries
Les projections sont formelles et décrivent une crise sanitaire mondiale en pleine accélération : d’ici 2050, la résistance aux antibiotiques pourrait causer plus de 10 millions de décès par an. Face à des traitements médicamenteux classiques de moins en moins efficaces, les bactéries évoluent pour devenir des « super-bactéries », proliférant aussi bien dans les hôpitaux que dans les stations d’épuration, les élevages ou les fermes piscicoles.
Pour contrer cette menace, les scientifiques se tournent vers des technologies de pointe. À l’Université de Californie à San Diego (UC San Diego), des chercheurs viennent d’appliquer des outils génétiques avancés pour neutraliser ces mécanismes de résistance. Leurs travaux, menés conjointement par les laboratoires des professeurs Ethan Bier et Justin Meyer de l’École des sciences biologiques, proposent une méthode inédite : supprimer les éléments résistants directement au sein des populations bactériennes.
Détourner la génétique pour modifier les populations

L’approche développée par l’équipe californienne s’inspire des systèmes de « forçage génétique » (gene drives), déjà utilisés chez les insectes pour enrayer la propagation de parasites comme ceux responsables du paludisme. Leur nouvel outil, baptisé pPro-MobV, repose sur la technologie CRISPR et constitue une seconde génération de la génétique dite « pro-active » (Pro-AG).
Ethan Bier, membre du département de biologie cellulaire et du développement, explique la logique de cette ingénierie : « Avec pPro-MobV, nous avons transposé la réflexion sur le forçage génétique des insectes aux bactéries en tant qu’outil d’ingénierie des populations. Avec cette nouvelle technologie basée sur CRISPR, nous pouvons prendre quelques cellules et les laisser agir pour neutraliser la résistance aux antibiotiques dans une vaste population cible. »
Cette avancée s’appuie sur des recherches antérieures. En 2019, le laboratoire du professeur Bier avait collaboré avec le groupe du professeur Victor Nizet, de l’École de médecine de l’UC San Diego. Ensemble, ils avaient conçu le concept initial de Pro-AG. Le principe ? Introduire une « cassette » génétique capable de se copier entre les génomes bactériens pour inactiver les composants résistants. Cette cassette cible les plasmides — des molécules d’ADN circulaires qui se répliquent dans les cellules — et restaure ainsi la sensibilité des bactéries aux traitements antibiotiques.
Infiltrer les forteresses bactériennes

Comment cet outil se propage-t-il concrètement ? Ethan Bier et ses collègues ont mis au point un système qui diffuse les composants de la cassette CRISPR via un transfert conjugal, un processus comparable à l’accouplement chez les bactéries. Comme décrit dans leur publication au sein de la revue Nature npj Antimicrobials and Resistance, le système pPro-MobV exploite un tunnel d’accouplement bactérien naturel pour transmettre les éléments neutralisants d’une cellule à l’autre.
Les chercheurs ont démontré l’efficacité de ce processus au cœur des biofilms. Ces communautés de micro-organismes, qui contaminent diverses surfaces, sont notoirement difficiles à éliminer par les méthodes de nettoyage conventionnelles. Les biofilms jouent un rôle majeur dans la propagation des maladies et la majorité des infections graves, notamment parce qu’ils créent une couche protectrice empêchant la diffusion des antibiotiques.
L’enjeu dépasse le cadre clinique. « Le contexte du biofilm pour combattre la résistance aux antibiotiques est particulièrement important, car c’est l’une des formes de croissance bactérienne les plus difficiles à surmonter en clinique ou dans des environnements clos tels que les étangs d’aquaculture et les stations d’épuration », précise le professeur Bier. Il ajoute qu’une réduction de la transmission des animaux aux humains pourrait avoir un impact significatif, environ la moitié du problème de la résistance provenant de l’environnement.
Virus alliés et mécanismes de sécurité

Pour acheminer ce système génétique actif, l’équipe envisage d’utiliser des transporteurs naturels : les bactériophages, ou phages. Ces virus, compétiteurs évolutifs des bactéries, sont aujourd’hui ingéniés pour contourner les défenses bactériennes et insérer des facteurs perturbateurs dans les cellules. Les éléments pPro-MobV fonctionneraient ainsi de concert avec ces phages modifiés.
La sécurité du dispositif n’a pas été oubliée. Cette plateforme génétique peut intégrer un processus de haute efficacité nommé « délétion basée sur l’homologie ». Ce mécanisme agit comme une mesure de précaution, permettant de retirer la cassette génétique si cela s’avère nécessaire.
Justin Meyer, professeur au département d’écologie, comportement et évolution, qui étudie les adaptations des bactéries et des virus, souligne le changement de paradigme qu’implique cette découverte : « Cette technologie est l’une des rares méthodes dont j’ai connaissance qui peut inverser activement la propagation des gènes résistants aux antibiotiques, plutôt que de simplement ralentir ou gérer leur propagation. »
Selon la source : phys.org
Créé par des humains, assisté par IA.